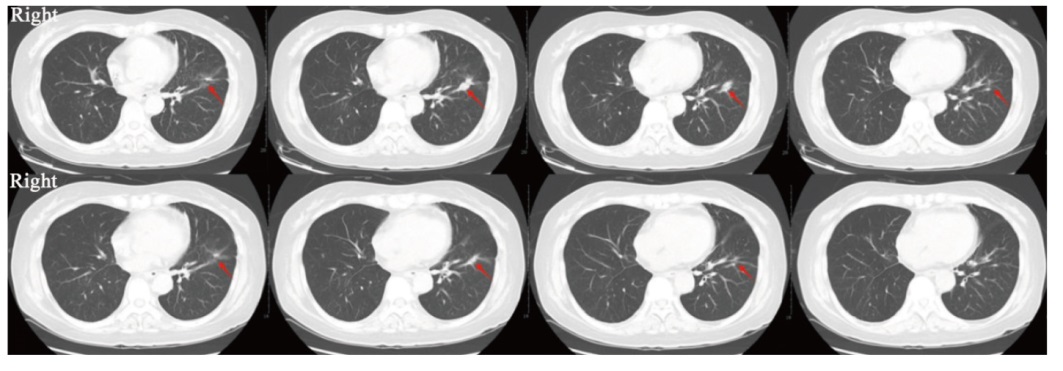

鞘内注射培美曲塞联合程序性死亡蛋白-1抑制剂治疗实体瘤脑膜转移的Ⅰ期临床研究
Phase Ⅰ study of intrathecal pemetrexed combined with programmed death-1 inhibitor for leptomeningeal metastases from solid tumors
The red arrow indicates the regressed primary lung lesion.

鞘内注射培美曲塞联合程序性死亡蛋白-1抑制剂治疗实体瘤脑膜转移的Ⅰ期临床研究 |
| 刘苗苗, 黄育珊, 杨国姿, 邰盼盼, 陈晓, 刘敏, 潘振宇 |
|
Phase Ⅰ study of intrathecal pemetrexed combined with programmed death-1 inhibitor for leptomeningeal metastases from solid tumors |
| LIU Miaomiao, HUANG Yushan, YANG Guozi, TAI Panpan, CHEN Xiao, LIU Min, PAN Zhenyu |
| 图4 第5例患者治疗前后肺部原发灶对比 |
| Fig. 4 Comparison of primary lung lesions before and after treatment in the fifth patient The red arrow indicates the regressed primary lung lesion. |
|